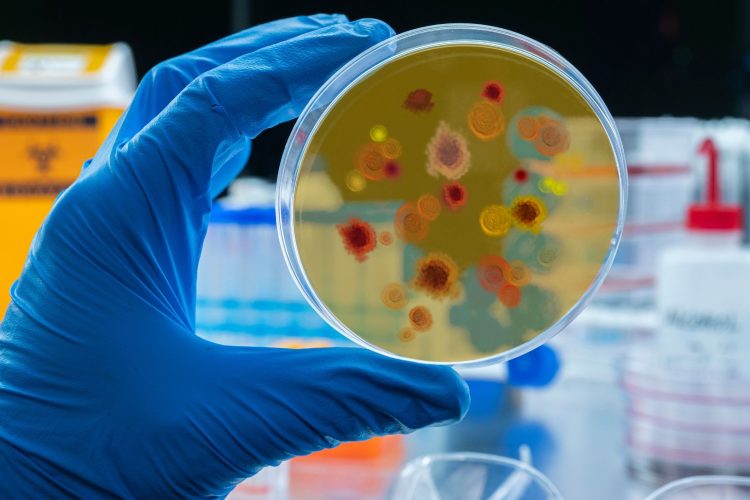
Νέο φάρμακο κατά της ελονοσίας με ισχυρά αποτελέσματα — ελπίδα κατά της ανθεκτικότητας

Η εταιρεία Novartis, σε συνεργασία με τη μη-κερδοσκοπική οργάνωση Medicines for Malaria Venture (MMV), αναπτύσσουν ένα νέο συνδυασμό φαρμάκου — τον GanLum (ganaplacide + lumefantrine) — με στόχο την αποτελεσματική αντιμετώπιση της ελονοσίας, συμπεριλαμβανομένων και των ανθεκτικών στελεχών.
Σύμφωνα με πρόσφατες δοκιμές φάσης ΙΙ / ΙΙΙ, ο συνδυασμός πέτυχε ποσοστά ίασης πάνω από 97 % (σε κάποιες αναφορές >99 %) σε ασθενείς (ενήλικες και παιδιά) με τη νόσο.
Μία από τις καινοτομίες είναι ότι ο σχεδιασμός της μορφής του lumefantrine (solid dispersion formulation) επιτρέπει χορήγηση μία φορά την ημέρα, αντί για τις παραδοσιακές πιο συχνές δόσεις, βελτιώνοντας τη συμμόρφωση της θεραπείας.
Η ανάγκη για νέα φάρμακα είναι πιεστική, καθώς η ανθεκτικότητα στα αμφιλεγόμενα φάρμακα της κατηγορίας των αρτεμισίνινών έχει αρχίσει να αυξάνεται σε περιοχές της ανατολικής και νότιας Αφρικής. Η ganaplacide διαθέτει νέο μηχανισμό δράσης (μη-αρτεμισινίνης) και στοχεύει τόσο το αίμα του ασθενούς όσο και τη μετάδοση του παρασίτου.
Οι ερευνητές σημειώνουν ότι αν εγκριθεί, ο νέος συνδυασμός μπορεί να αποτελέσει κρίσιμο «όπλο» στη μάχη κατά της ελονοσίας, ιδίως σε χώρες με υψηλό φορτίο νόσου και όπου η αντίσταση αυξάνει. Η έναρξη μεγαλύτερων δοκιμών και η εξασφάλιση προσβασιμότητας στις περιοχές αυτές είναι τα επόμενα βήματα.
Πηγή: Reuters